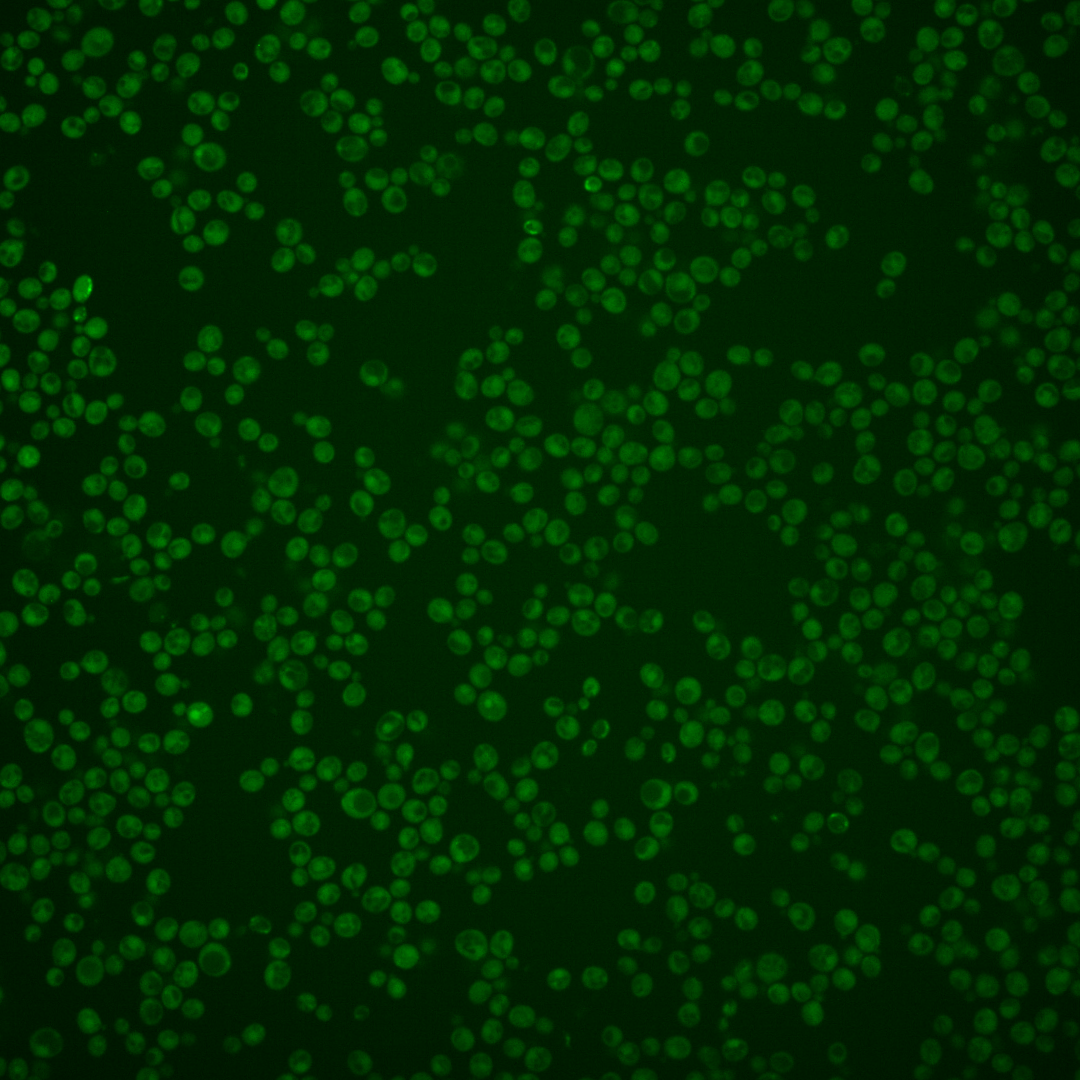
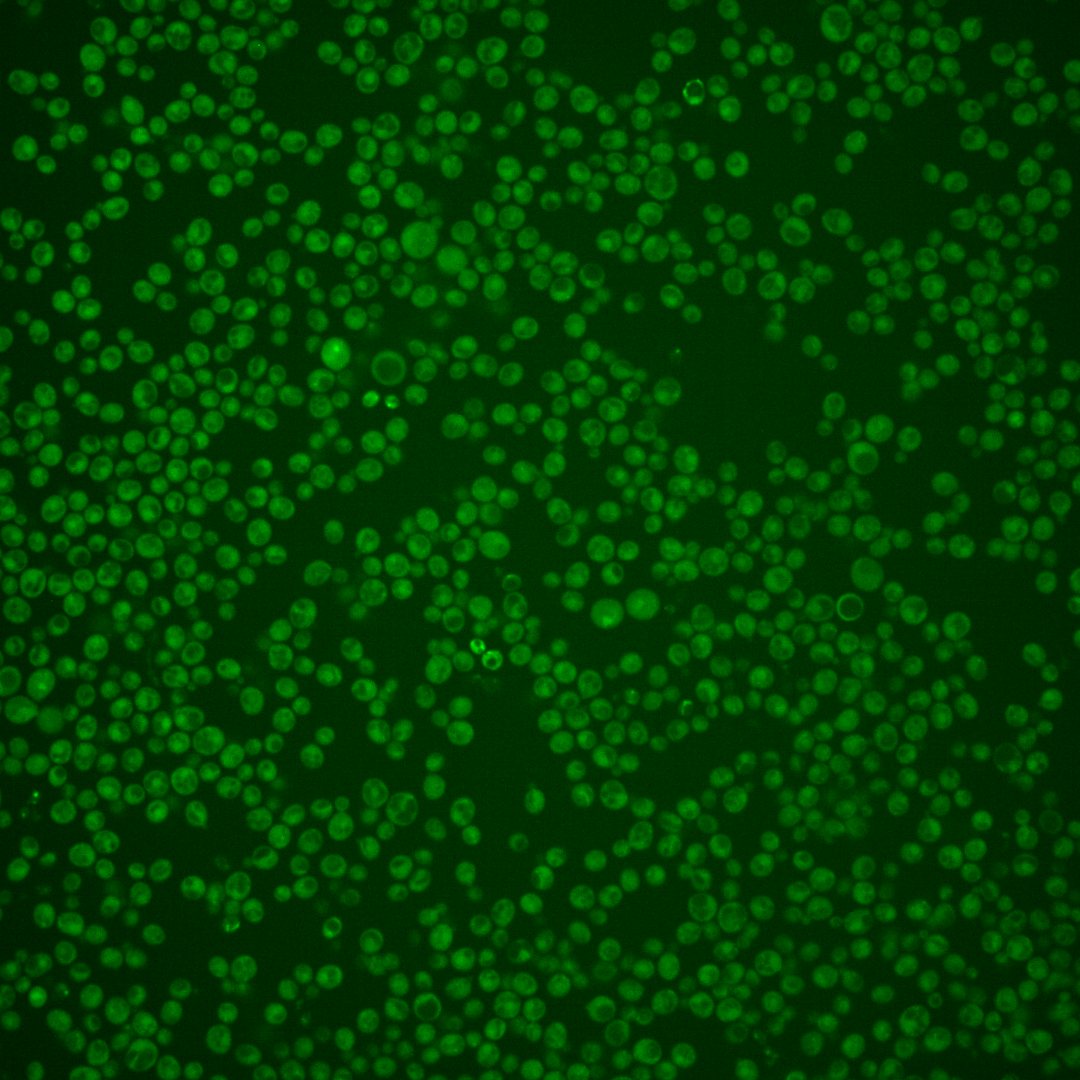
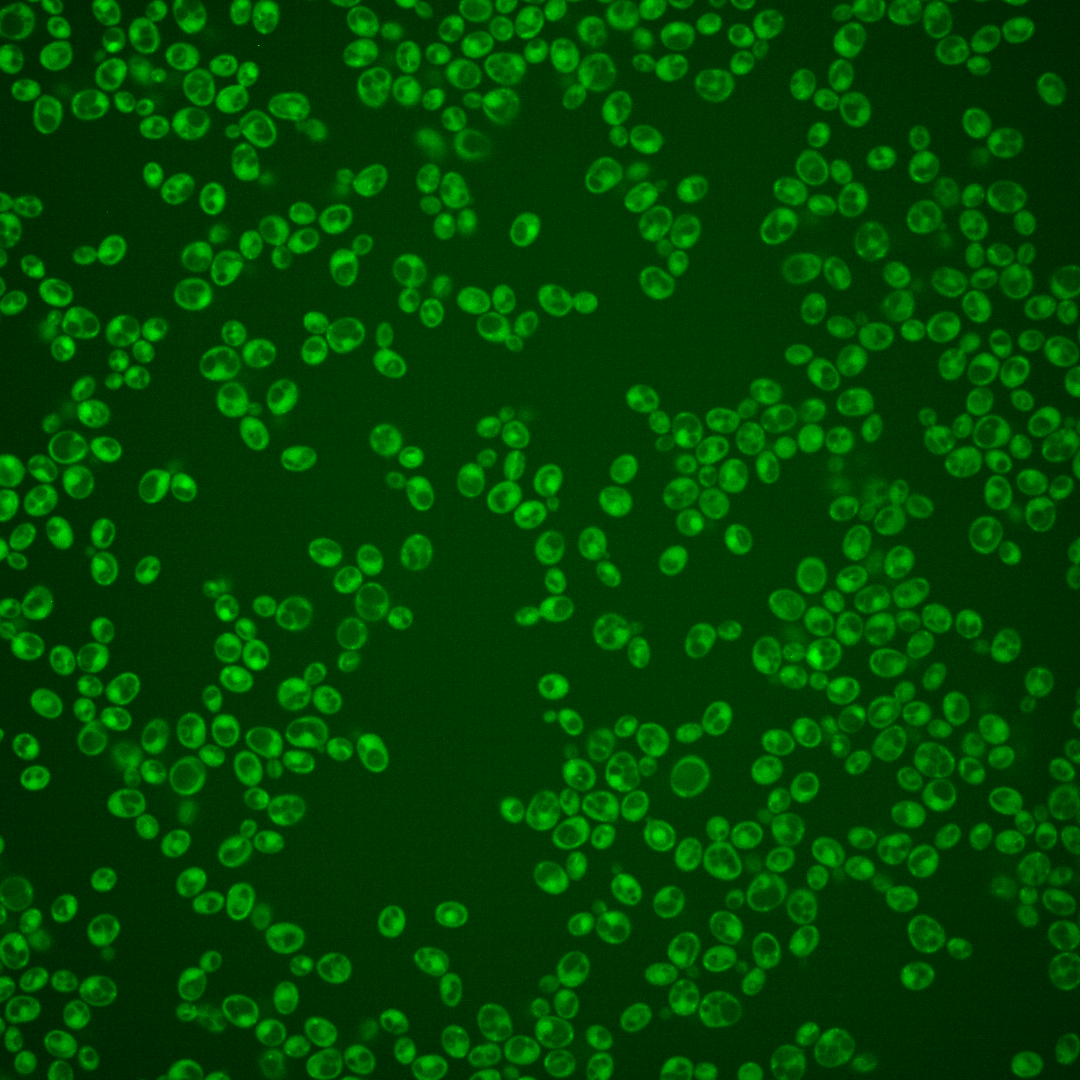
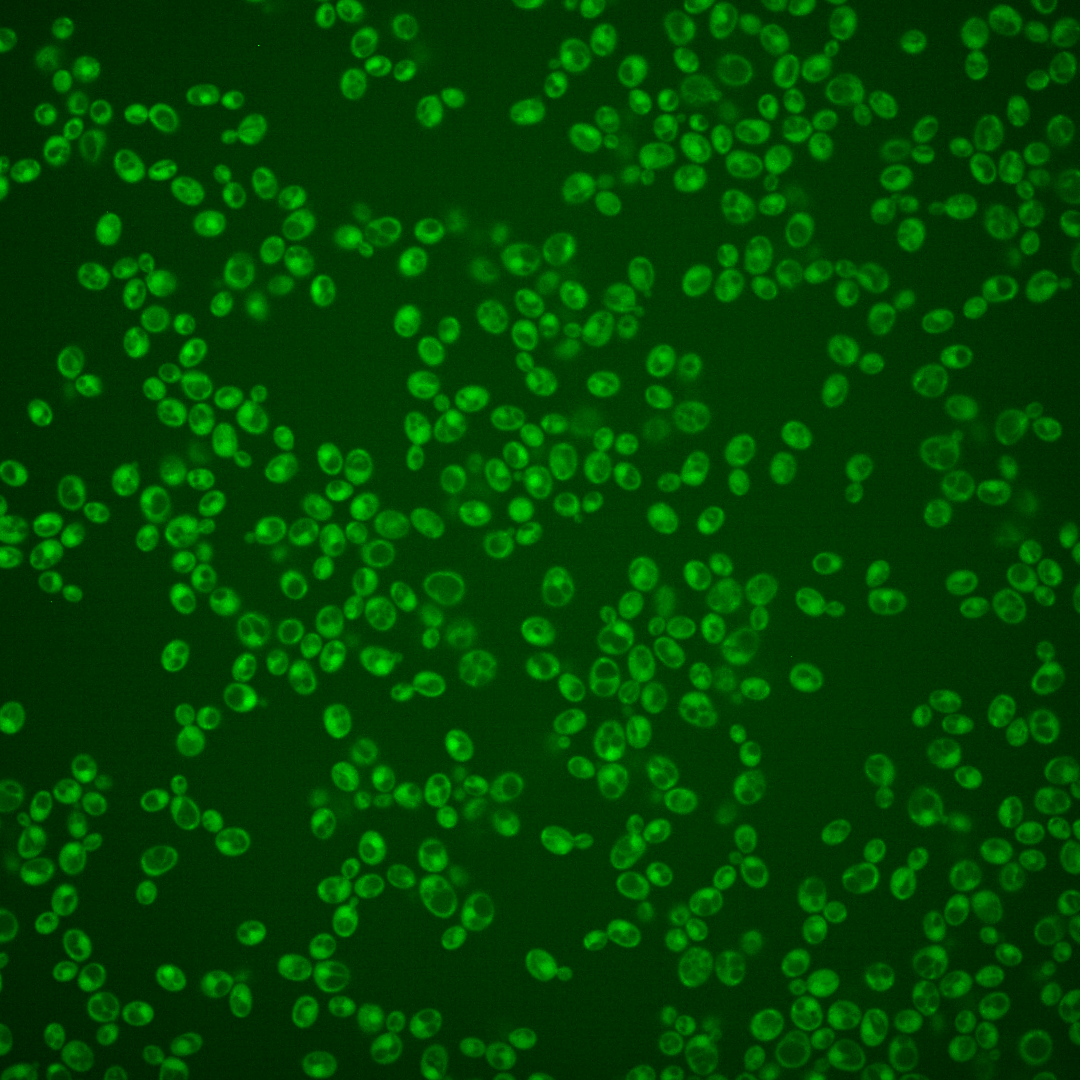
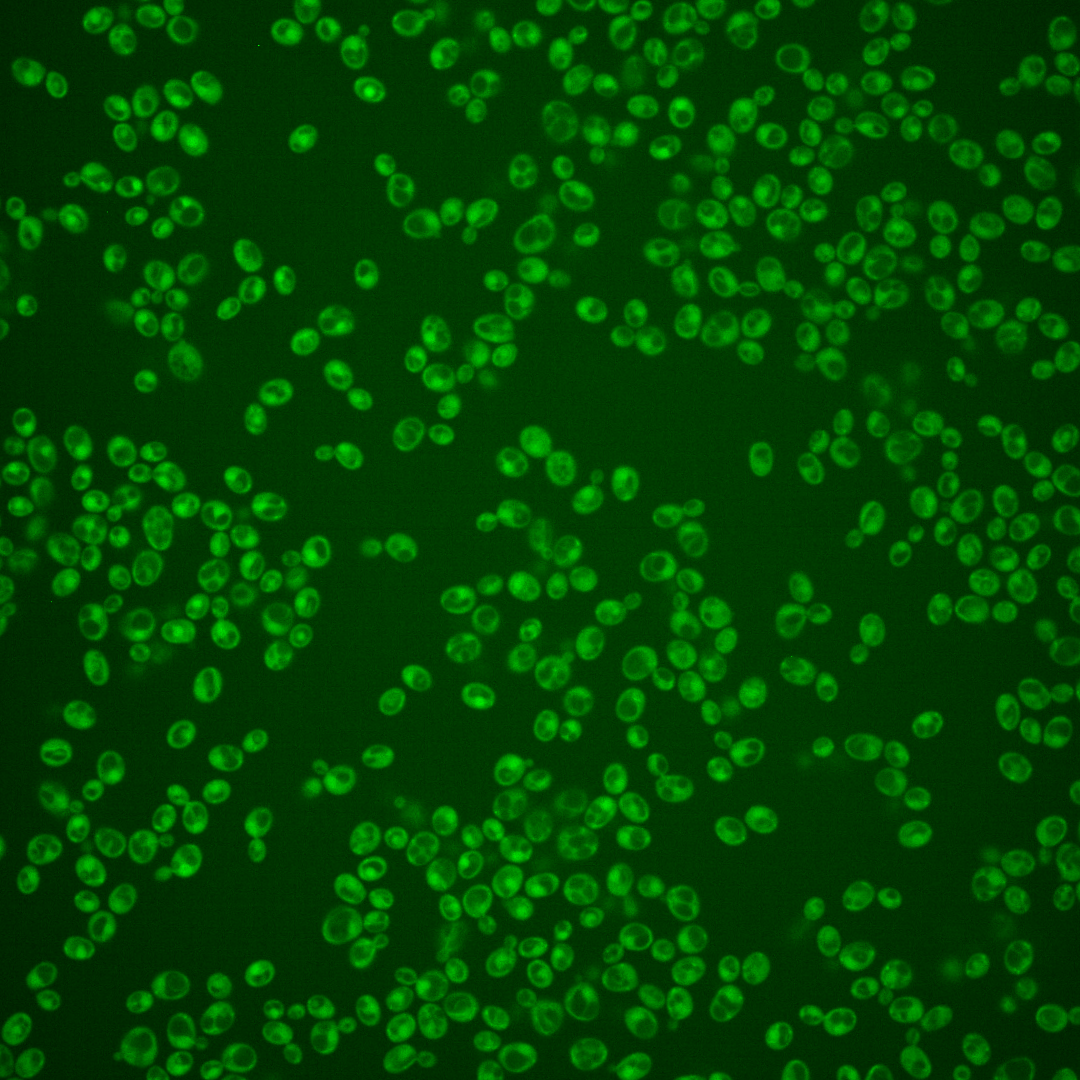
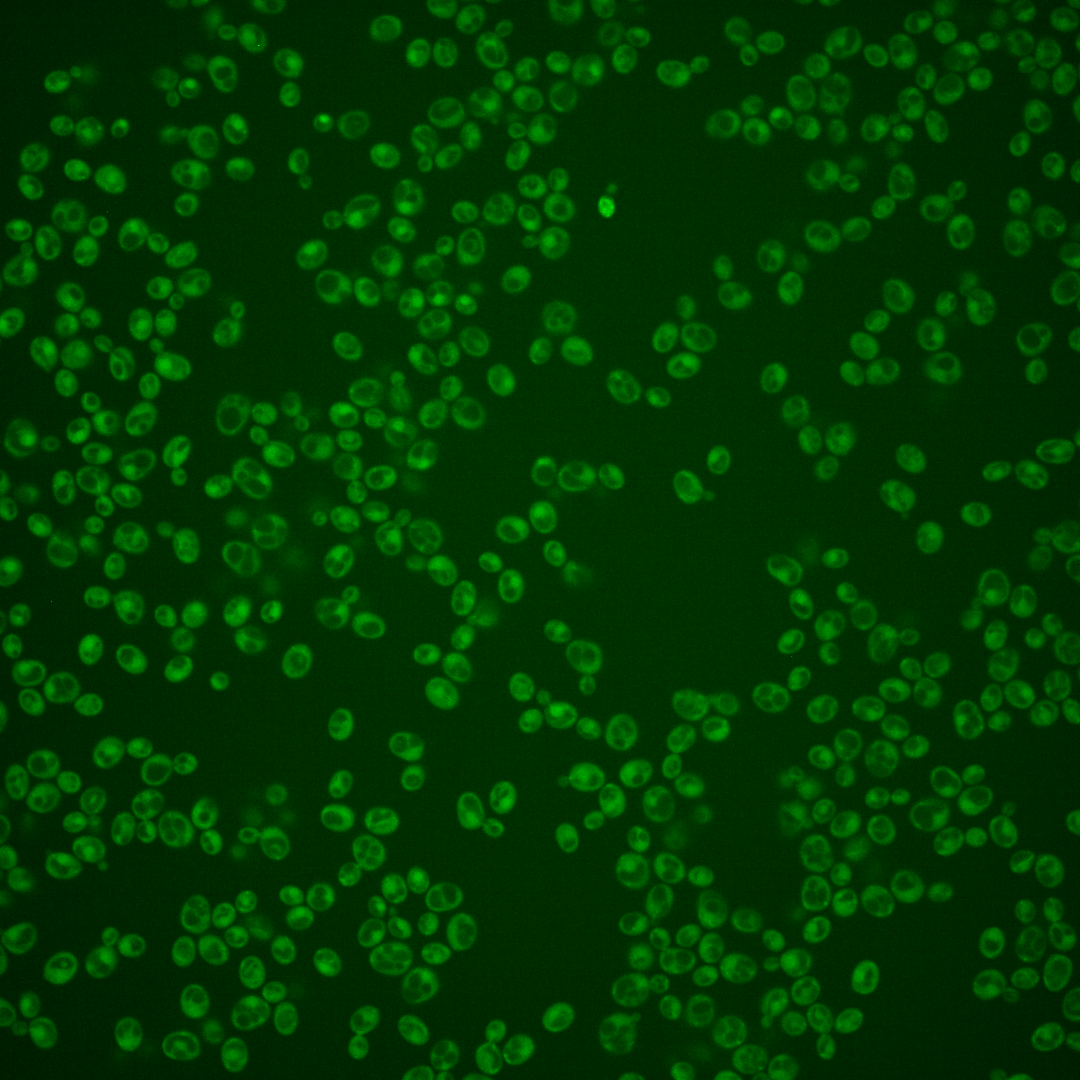

| Standard name | |
|---|---|
| Human Ortholog | |
| Description | Putative mannose-ethanolamine phosphate phosphodiesterase; involved in GPI-anchor remodeling prior to the attachment of cell wall proteins to beta 1,3-glucan, removing ethanolamine phosphate from the first mannose of GPI anchors; mutants display elevated Ca2+-dependent signaling resulting in secondary actin polarization and Golgi inheritance defects; enzyme is Mn2+-dependent; mutants have cell division cycle defect and fragile cell walls |
Micrographs




















































































Sub-cellular Localization
Yeast GFP Assignment
Protein Abundance
Localization Change
External localization resources
| ensLOC | DeepLoc | |||||||||||||||||||||||
|---|---|---|---|---|---|---|---|---|---|---|---|---|---|---|---|---|---|---|---|---|---|---|---|---|
| Localization | WT1 | WT2 | WT3 | RAP60 | RAP140 | RAP220 | RAP300 | RAP380 | RAP460 | RAP540 | RAP620 | RAP700 | HU80 | HU120 | HU160 | rpd3Δ_1 | rpd3Δ_2 | rpd3Δ_3 | WT1 | WT2 | WT3 | AF100 | AF140 | AF180 |
| Cortical Patches | 0 | 0 | 0 | 0 | 0 | 0 | 0 | 0 | 0 | 0 | 0 | 1 | 0 | 0 | 0 | 0 | 0 | 0 | 3 | 1 | 1 | 0 | 2 | 8 |
| Bud | 0 | 0 | 1 | 2 | 4 | 3 | 0 | 8 | 6 | 6 | 9 | 3 | 1 | 2 | 0 | 0 | 0 | 0 | 1 | 0 | 1 | 2 | 8 | 15 |
| Bud Neck | 0 | 0 | 0 | 0 | 0 | 0 | 0 | 2 | 3 | 3 | 1 | 3 | 0 | 0 | 0 | 0 | 0 | 0 | 2 | 0 | 0 | 1 | 3 | 4 |
| Bud Site | 0 | 0 | 0 | 0 | 0 | 0 | 0 | 0 | 0 | 0 | 0 | 0 | 0 | 0 | 0 | 0 | 0 | 0 | – | – | – | – | – | – |
| Cell Periphery | 1 | 0 | 0 | 1 | 1 | 0 | 0 | 1 | 2 | 0 | 0 | 2 | 3 | 0 | 0 | 2 | 3 | 0 | 0 | 2 | 0 | 0 | 1 | 2 |
| Cytoplasm | 162 | 112 | 161 | 118 | 162 | 223 | 209 | 316 | 173 | 209 | 129 | 178 | 290 | 473 | 503 | 203 | 179 | 126 | 136 | 105 | 107 | 225 | 301 | 328 |
| Endoplasmic Reticulum | 0 | 0 | 0 | 1 | 0 | 0 | 1 | 1 | 1 | 0 | 1 | 0 | 0 | 0 | 2 | 13 | 18 | 3 | 1 | 0 | 3 | 0 | 1 | 3 |
| Endosome | 0 | 0 | 0 | 0 | 4 | 0 | 0 | 0 | 0 | 0 | 0 | 0 | 0 | 1 | 0 | 7 | 3 | 4 | 4 | 1 | 5 | 3 | 3 | 5 |
| Golgi | 0 | 0 | 0 | 0 | 0 | 0 | 0 | 0 | 0 | 1 | 0 | 0 | 0 | 0 | 0 | 1 | 0 | 0 | 0 | 1 | 0 | 0 | 1 | 1 |
| Mitochondria | 47 | 5 | 2 | 10 | 12 | 65 | 72 | 64 | 69 | 97 | 100 | 111 | 0 | 0 | 0 | 12 | 1 | 3 | 28 | 9 | 25 | 12 | 20 | 18 |
| Nucleus | 0 | 0 | 0 | 0 | 2 | 0 | 0 | 3 | 1 | 2 | 0 | 1 | 1 | 0 | 1 | 3 | 0 | 1 | 0 | 1 | 0 | 0 | 0 | 1 |
| Nuclear Periphery | 0 | 1 | 0 | 0 | 0 | 0 | 0 | 1 | 0 | 0 | 0 | 1 | 0 | 0 | 1 | 0 | 0 | 0 | 0 | 0 | 0 | 0 | 1 | 0 |
| Nucleolus | 0 | 0 | 0 | 0 | 0 | 0 | 0 | 2 | 0 | 1 | 0 | 0 | 0 | 1 | 0 | 0 | 0 | 0 | 0 | 0 | 0 | 0 | 0 | 0 |
| Peroxisomes | 0 | 0 | 0 | 0 | 0 | 1 | 0 | 0 | 0 | 2 | 0 | 0 | 0 | 0 | 1 | 0 | 0 | 0 | 0 | 0 | 0 | 0 | 0 | 0 |
| SpindlePole | 0 | 0 | 1 | 0 | 0 | 1 | 2 | 4 | 1 | 9 | 3 | 0 | 0 | 0 | 0 | 0 | 0 | 0 | 0 | 1 | 2 | 1 | 6 | 3 |
| Vac/Vac Membrane | 0 | 0 | 1 | 1 | 2 | 4 | 2 | 3 | 4 | 2 | 0 | 2 | 0 | 2 | 0 | 32 | 22 | 14 | 14 | 7 | 7 | 6 | 11 | 36 |
| Unique Cell Count | 183 | 114 | 163 | 124 | 174 | 247 | 243 | 361 | 213 | 261 | 188 | 235 | 290 | 475 | 506 | 233 | 196 | 140 | 201 | 135 | 162 | 257 | 371 | 438 |
| Labelled Cell Count | 210 | 118 | 166 | 133 | 187 | 297 | 286 | 405 | 260 | 332 | 243 | 302 | 295 | 479 | 508 | 273 | 226 | 151 | 201 | 135 | 162 | 257 | 371 | 438 |
Yeast GFP Assignment
Protein Abundance
| Screen | WT1 | WT2 | WT3 | RAP60 | RAP140 | RAP220 | RAP300 | RAP380 | RAP460 | RAP540 | RAP620 | RAP700 | HU80 | HU120 | HU160 | rpd3Δ_1 | rpd3Δ_2 | rpd3Δ_3 | AF100 | AF140 | AF180 |
|---|---|---|---|---|---|---|---|---|---|---|---|---|---|---|---|---|---|---|---|---|---|
| Mean Cell GFP Intensity (1e-4) | 3.3 | 4.0 | 3.8 | 3.5 | 4.0 | 3.1 | 2.8 | 3.3 | 3.0 | 2.9 | 2.8 | 2.6 | 4.1 | 3.9 | 4.0 | 5.1 | 6.5 | 5.8 | 3.8 | 4.2 | 4.9 |
| Std Deviation (1e-4) | 0.8 | 1.0 | 1.6 | 1.6 | 1.9 | 1.2 | 0.9 | 1.3 | 1.7 | 1.7 | 1.0 | 1.0 | 1.0 | 1.0 | 1.1 | 2.0 | 3.4 | 1.8 | 0.9 | 1.5 | 1.3 |
| Intensity Change (Log2) | – | – | – | -0.09 | 0.1 | -0.26 | -0.44 | -0.2 | -0.31 | -0.39 | -0.42 | -0.54 | 0.13 | 0.06 | 0.11 | 0.45 | 0.8 | 0.62 | 0.02 | 0.16 | 0.37 |
Localization Change
| Localization | RAP60 | RAP140 | RAP220 | RAP300 | RAP380 | RAP460 | RAP540 | RAP620 | RAP700 | HU80 | HU120 | HU160 | rpd3Δ_1 | rpd3Δ_2 | rpd3Δ_3 |
|---|---|---|---|---|---|---|---|---|---|---|---|---|---|---|---|
| Actin | – | – | – | – | – | – | – | – | – | – | – | – | – | – | – |
| Bud | – | – | – | – | – | – | – | – | – | – | – | – | 0 | 0 | 0 |
| Bud Neck | – | – | – | – | – | – | – | – | – | – | – | – | 0 | 0 | 0 |
| Bud Site | – | – | – | – | – | – | – | – | – | – | – | – | 0 | 0 | 0 |
| Cell Periphery | – | – | – | – | – | – | – | – | – | – | – | – | 0 | 0 | 0 |
| Cyto | – | – | – | – | – | – | – | – | – | – | – | – | – | – | – |
| Endoplasmic Reticulum | – | – | – | – | – | – | – | – | – | – | – | – | 0 | 0 | 0 |
| Endosome | – | – | – | – | – | – | – | – | – | – | – | – | 0 | 0 | 0 |
| Golgi | – | – | – | – | – | – | – | – | – | – | – | – | 0 | 0 | 0 |
| Mitochondria | – | – | – | – | – | – | – | – | – | – | – | – | 0 | 0 | 0 |
| Nuclear Periphery | – | – | – | – | – | – | – | – | – | – | – | – | 0 | 0 | 0 |
| Nuc | – | – | – | – | – | – | – | – | – | – | – | – | – | – | – |
| Nucleolus | – | – | – | – | – | – | – | – | – | – | – | – | 0 | 0 | 0 |
| Peroxisomes | – | – | – | – | – | – | – | – | – | – | – | – | 0 | 0 | 0 |
| SpindlePole | – | – | – | – | – | – | – | – | – | – | – | – | 0 | 0 | 0 |
| Vac | – | – | – | – | – | – | – | – | – | – | – | – | – | – | – |
| Cortical Patches | – | – | – | – | – | – | – | – | – | – | – | – | 0 | 0 | 0 |
| Cytoplasm | – | – | – | – | – | – | – | – | – | – | – | – | 0 | 0 | 0 |
| Nucleus | – | – | – | – | – | – | – | – | – | – | – | – | 0 | 0 | 0 |
| Vacuole | – | – | – | – | – | – | – | – | – | – | – | – | 4.6 | 4.1 | 3.8 |
External localization resources
Images






























Protein Concentration and Protein Localization Data
| R1 | R2 | R3 | ||||||||||||||||
|---|---|---|---|---|---|---|---|---|---|---|---|---|---|---|---|---|---|---|
| G1 Pre-START | G1 Post-START | S/G2 | Metaphase | Anaphase | Telophase | G1 Pre-START | G1 Post-START | S/G2 | Metaphase | Anaphase | Telophase | G1 Pre-START | G1 Post-START | S/G2 | Metaphase | Anaphase | Telophase | |
| Concentration | 0.8933 | 0.3667 | 0.2023 | 0.6264 | 0.1981 | 0.5349 | 1.6718 | 1.4027 | 1.569 | 1.2434 | 1.2951 | 1.5461 | 2.1413 | 2.4126 | 2.4902 | 2.7481 | 2.0697 | 2.0894 |
| Actin | 0.064 | 0.0004 | 0.0058 | 0.0216 | 0.0089 | 0.0235 | 0.0568 | 0.0169 | 0.0078 | 0.0036 | 0.0113 | 0.0023 | 0.045 | 0.0033 | 0.0218 | 0.0003 | 0.0019 | 0.0043 |
| Bud | 0.0019 | 0.006 | 0.0004 | 0.0005 | 0.0011 | 0.0044 | 0.0015 | 0.006 | 0.0037 | 0.0004 | 0.001 | 0.0003 | 0.0008 | 0.0013 | 0.0017 | 0.0005 | 0.0001 | 0.0002 |
| Bud Neck | 0.0068 | 0.0002 | 0.0046 | 0.0058 | 0.0007 | 0.002 | 0.0035 | 0.0005 | 0.001 | 0.0002 | 0.0023 | 0.0008 | 0.0123 | 0.0018 | 0.0005 | 0.0001 | 0.0005 | 0.0003 |
| Bud Periphery | 0.0066 | 0.0012 | 0.0007 | 0.0012 | 0.0009 | 0.0087 | 0.0037 | 0.0111 | 0.0036 | 0.0011 | 0.0014 | 0.0015 | 0.0021 | 0.0029 | 0.0037 | 0.0015 | 0.0001 | 0.0004 |
| Bud Site | 0.0116 | 0.0036 | 0.0019 | 0.0042 | 0.0208 | 0.0013 | 0.013 | 0.0149 | 0.0123 | 0.0003 | 0.0056 | 0.0001 | 0.0065 | 0.0077 | 0.0049 | 0.0001 | 0.0002 | 0.0002 |
| Cell Periphery | 0.0013 | 0.0006 | 0.0003 | 0.0005 | 0.0002 | 0.0002 | 0.001 | 0.001 | 0.001 | 0.0001 | 0.0002 | 0.0001 | 0.0004 | 0.0011 | 0.0003 | 0.0002 | 0.0001 | 0.0001 |
| Cytoplasm | 0.1171 | 0.2832 | 0.2191 | 0.2912 | 0.182 | 0.2894 | 0.0632 | 0.1687 | 0.0668 | 0.0914 | 0.0613 | 0.113 | 0.1005 | 0.1506 | 0.1098 | 0.1137 | 0.1794 | 0.1934 |
| Cytoplasmic Foci | 0.0621 | 0.0476 | 0.0705 | 0.0307 | 0.096 | 0.0377 | 0.0406 | 0.016 | 0.0382 | 0.0634 | 0.0666 | 0.04 | 0.0381 | 0.0253 | 0.0294 | 0.0299 | 0.0576 | 0.0261 |
| Eisosomes | 0.0011 | 0.0001 | 0.0004 | 0.0004 | 0.0001 | 0.0002 | 0.0011 | 0.0006 | 0.0006 | 0.0001 | 0.0002 | 0.0002 | 0.0005 | 0.0003 | 0.0005 | 0.0003 | 0.0003 | 0.0001 |
| Endoplasmic Reticulum | 0.0143 | 0.0073 | 0.0046 | 0.008 | 0.005 | 0.0033 | 0.0045 | 0.0021 | 0.002 | 0.0025 | 0.0026 | 0.0008 | 0.0042 | 0.0051 | 0.0033 | 0.0048 | 0.0021 | 0.0031 |
| Endosome | 0.0346 | 0.0323 | 0.0419 | 0.0389 | 0.1158 | 0.0199 | 0.0328 | 0.0105 | 0.0344 | 0.0338 | 0.0332 | 0.0052 | 0.0336 | 0.0167 | 0.0214 | 0.0826 | 0.018 | 0.0078 |
| Golgi | 0.0123 | 0.0017 | 0.0065 | 0.0083 | 0.0121 | 0.0031 | 0.0084 | 0.0018 | 0.0116 | 0.0118 | 0.0097 | 0.001 | 0.0051 | 0.0016 | 0.0033 | 0.0043 | 0.002 | 0.0009 |
| Lipid Particles | 0.0286 | 0.0083 | 0.0155 | 0.03 | 0.0392 | 0.0055 | 0.0204 | 0.0075 | 0.0066 | 0.0099 | 0.0232 | 0.003 | 0.0165 | 0.0029 | 0.0065 | 0.0008 | 0.0011 | 0.0024 |
| Mitochondria | 0.0073 | 0.0013 | 0.0024 | 0.0015 | 0.003 | 0.0028 | 0.0078 | 0.0033 | 0.0135 | 0.0022 | 0.0402 | 0.0027 | 0.0057 | 0.0018 | 0.0039 | 0.0059 | 0.001 | 0.0011 |
| None | 0.5638 | 0.59 | 0.6016 | 0.5395 | 0.4877 | 0.5741 | 0.692 | 0.7213 | 0.7821 | 0.7728 | 0.696 | 0.8117 | 0.6658 | 0.7671 | 0.7687 | 0.7441 | 0.6959 | 0.7532 |
| Nuclear Periphery | 0.0168 | 0.003 | 0.0018 | 0.0042 | 0.0029 | 0.0022 | 0.0062 | 0.0006 | 0.0007 | 0.0011 | 0.0007 | 0.0046 | 0.0085 | 0.002 | 0.0035 | 0.0018 | 0.0037 | 0.0005 |
| Nucleolus | 0.0015 | 0.0004 | 0.001 | 0.0005 | 0.001 | 0.0005 | 0.0024 | 0.0004 | 0.0008 | 0.0003 | 0.0006 | 0.0002 | 0.001 | 0.0005 | 0.0004 | 0.0002 | 0.002 | 0.0006 |
| Nucleus | 0.0041 | 0.0011 | 0.0016 | 0.0014 | 0.001 | 0.0012 | 0.0061 | 0.0009 | 0.0009 | 0.0005 | 0.0004 | 0.0014 | 0.0112 | 0.0024 | 0.003 | 0.0007 | 0.0053 | 0.001 |
| Peroxisomes | 0.022 | 0.0014 | 0.0075 | 0.0037 | 0.009 | 0.0043 | 0.0231 | 0.0096 | 0.007 | 0.0011 | 0.0382 | 0.0084 | 0.0261 | 0.0007 | 0.0069 | 0.0007 | 0.0164 | 0.0021 |
| Punctate Nuclear | 0.0158 | 0.0027 | 0.0045 | 0.0042 | 0.0045 | 0.0138 | 0.0063 | 0.0006 | 0.002 | 0.0012 | 0.0031 | 0.0014 | 0.0094 | 0.0013 | 0.0038 | 0.0003 | 0.0099 | 0.001 |
| Vacuole | 0.0044 | 0.0067 | 0.0064 | 0.003 | 0.0069 | 0.0014 | 0.004 | 0.0048 | 0.0029 | 0.0016 | 0.0018 | 0.001 | 0.0056 | 0.0033 | 0.0023 | 0.0051 | 0.0018 | 0.0011 |
| Vacuole Periphery | 0.0021 | 0.0009 | 0.0012 | 0.0008 | 0.0013 | 0.0005 | 0.0016 | 0.0007 | 0.0006 | 0.0006 | 0.0006 | 0.0004 | 0.001 | 0.0005 | 0.0006 | 0.0023 | 0.0004 | 0.0002 |
Sequencing Data
| R1 | R2 | |||||||||
|---|---|---|---|---|---|---|---|---|---|---|
| G1 Post-START | S/G2 | Metaphase | Anaphase | Telophase | G1 Post-START | S/G2 | Metaphase | Anaphase | Telophase | |
| Gene Expression | 25.791 | 19.38 | 15.3726 | 31.4654 | 22.7774 | 26.1503 | 30.7441 | 31.9233 | 24.8766 | 37.7173 |
| Translational Efficiency | 1.6086 | 1.7274 | 1.9237 | 0.9368 | 1.3776 | 1.3854 | 1.217 | 0.8725 | 1.288 | 0.7869 |
Hit Data
| Dataset | Hit |
|---|---|
| Protein Concentration | ✘ |
| Protein Localization | ✘ |
| Gene Expression | ✘ |
| Translational Efficiency | ✘ |
Endocytosis
| Temp | Actin Patch (Sac6-tdTomato) | Cortical Patch (Sla1-GFP) | Late Endosome (Snf7-GFP) | Vacuole (Vph1-GFP) |
|---|---|---|---|---|
| 37℃ | ||||
| RT |
Cell Cycle Omics
CYCLoPs (Cdc1-GFP)
| Gene / Allele | Actin Patch (Sac6-tdTomato) | Cortical Patch (Sla1-GFP) | Late Endosome (Snf7-GFP) | Vacuole (Sac6-tdTomato) |
|---|
| Gene | Images |
|---|
| Gene | Images |
|---|
Images are not yet available
Images are not yet available